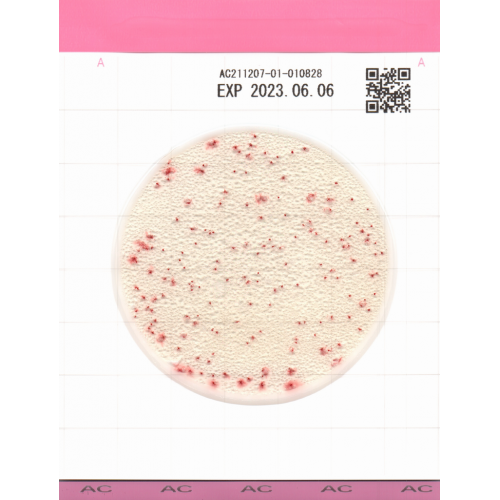
Compact Dry AC - Mediu de Cultură Uscat pentru Numărarea Totală Aerobă

Teste de sanitatie 3M Clean-Trace ATP
Transport Gratuit
Pentru comenzi peste 500 lei
Calitatea produselor garantata
Un nivel ridicat de calitate va determina o satisfacție mai deplină a clientului
Neogen Clean-Trace Surface ATP Test Swab reprezinta solutia profesionala pentru verificarea eficientei proceselor de curatare si sanitizare in industria alimentara, farmaceutica si in facilitatile medicale. Acest sistem de testare ATP (adenozin trifosfat) ofera rezultate instant si precise, permitand luarea deciziilor in timp real pentru controlul igienei.
Specificatii Tehnice
| Produs | Clean Trance® Tampoane ATP |
| Producator | Neogen |
| Tip test | Prelevare probe ATP |
| Aplicatie | Testare Suprafete |
| Unitate masura | RLU (Relative Light Units) |
| Timp rezultat | 8 secunde |
| Depozitare | 4-8 C |
| Compatibilitate | Plu |
| Ambalare | 100 buc |
Set de produse


21.780,00 Lei
Fără TVA: 18.000,00 Lei